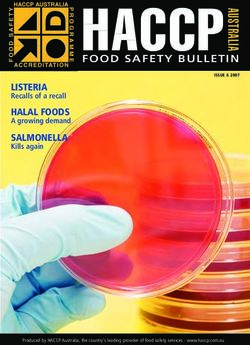
HACCP A FOOD SAFETY BULLETIN - LISTERIA

Improving Access to Healthy Food: A Community Planning Tool - November 2005
←
→
Page content transcription
If your browser does not render page correctly, please read the page content below
Improving Access to Healthy Food:
A Community Planning Tool
November 2005
COLUMBUS HEALTH
DEPARTMENTTable of Contents Introduction………………………………………………….. 1 Conducting a Community Food Assessment……………. 3 Developing an Action Plan………………………………… 6 Evaluation…………………………………………………… 9 Engaging the Community…………………………………. 11 Getting People to the Table………………………………. 14 Examples of Food Access Strategies……………………. 15 Acknowledgments / References………………………….. 27 Appendix A: Food Access Case Studies………………. 29
Improving Access to Healthy Food: A Community Planning Tool
INTRODUCTION
Good nutrition is a critical part of an individual’s health, well-being and quality of life.
Many major causes of disease and death in the United States are related to poor
nutrition and a lack of physical activity, including heart disease, diabetes, overweight
and obesity, high blood pressure, osteoporosis, and certain cancers.
Poor nutrition can also impact day-to-day life by affecting concentration, work or
school performance. For children, a poor diet can have a significant effect on proper
growth and development. Low-income populations often experience a greater
burden from chronic diseases caused by poor nutrition; however, these problems
affect entire communities, cities and states – which is evident in rising health care
costs and insurance costs.
What does it mean to “Eat Healthy”?
People who want to follow a healthier eating plan should try to:
• Increase the amount of fruits and vegetables eaten as part of an everyday diet.
► Buy fresh produce in season for the best prices;
► Select canned fruits and vegetables as a convenient way to include more
produce in the diet. Look for fruits canned in light syrup or natural juices;
► For vegetables, choose “No Salt Added” versions if sodium intake is a
concern;
► Choose frozen fruits and vegetables, which are available year round and
are rich in important nutrients.
• Choose whole grain products when possible. Look for “Whole Wheat Flour” or
“Whole Wheat” as the first ingredient on the nutrition facts label.
• Include up to three servings of fat-free (skim) or low-fat (1-2%) milk and milk
products each day.
• Select lean meats, poultry, fish, beans, eggs, and nuts as quality protein
sources.
• Focus on choosing food items low in saturated fats, trans-fats, cholesterol, salt
(sodium), and added sugars.
• Use proper serving sizes for all foods to prevent excess calorie consumption.
Information on the correct serving sizes for each food group is available at
www.Mypyramid.gov.
Many factors can affect the nutritional health of both individuals and communities,
including an individual’s knowledge about healthy nutrition, cultural practices related
to food choices, and having access to information about an adequate and
healthy diet.
Columbus Health Department
1Improving Access to Healthy Food: A Community Planning Tool
Barriers to healthy eating
Although healthy eating is important to good health, there are often barriers that
make it difficult. Examples of these barriers include:
• Dependence on small “corner groceries” that generally have limited food choices
and higher prices than supermarkets.
• Lack of accessible transportation to food resources.
• Stores that have inconvenient hours of operation.
• Easy access to fast food restaurants that typically serve high-fat and high-sodium
(salty) foods and offer big portion sizes at low prices.
• Schools providing easy access to sodas and other non-nutritious foods containing
empty calories and excess sugar.
What communities can do
Despite these barriers to healthy eating, communities are finding creative ways to
make nutritious food more accessible to their residents. “Improving Access to
Healthy Food: A Community Planning Tool,” has been developed as a self-help
resource for anyone wanting to work with others to find ways to bring healthier foods
into their neighborhood.
This document outlines a process that communities can follow to:
1. Determine whether healthy foods can be found in a specific community;
2. Develop specific strategies to bring more healthy foods into that community;
and
3. Determine whether these strategies are effective.
The three-part process of Assessment, Action Planning, and Evaluation is
a proven method that can be used to increase the availability of healthy foods in your
area and improve the health of those in the community.
Assessment Action Plan Evaluation
Recruit
Participants
Participants Evaluation
Purpose
Determine ASSESSMENT ACTION PLAN
Goals
RESULTS Group IMPLEMENTATION Evaluation
Process Method
Plan Process
Action Plan Evaluation
Format Questions
Define
Community Strategy
Improvements
Columbus Health Department
2Improving Access to Healthy Food: A Community Planning Tool
Part 1. Conducting a Community Food
Assessment
What is a Community Food Assessment?
A community food assessment is a process of gathering information that answers
some questions about the food available in your area -- questions such as: what food
is available, where it can be found, and what foods may be lacking? The assessment
gathers a variety of facts, examples, and perspectives to tell the story of what is
happening with the community's food system. Community food assessments can be
powerful tools for raising awareness of food system issues and for creating lasting,
positive change in a community.
While the assessment requires a lot of work, it is a critical step in working to increase
access to healthy foods. The assessment informs residents about problems with
their local food system. It provides the necessary groundwork for suggesting
strategies that will bring healthier foods into the community and it helps the
community prioritize its efforts.
Each community food assessment is unique based on a variety of factors, including
the assessment’s goals and method, the participants, and the resources available to
conduct the assessment. However, all food assessments have some characteristics
in common. They identify and build on existing community resources, and they often
use community members to develop them.
The process of developing your assessment can be broken down into six basic steps:
Step 1 - Recruit participants / Organize your assessment team. A community
food assessment requires significant time and resources to plan and carry out.
Ideally, the food assessment is planned, conducted and used by people living and
working in the community. Community members can play important roles, not only in
planning, but also in recruiting other participants and in gathering assessment
information. Perhaps more importantly, working with community members can help
ensure that the assessment process is accepted by the community and is
accountable to its concerns.
Step 2 - Determine the purposes and goals of the assessment. Two major
questions that need to be answered are:
• What does your group want to know, and
• Why?
In order to get these answers, each member of the assessment team should first
identify his or her own goals and interests related to the community’s food system.
Columbus Health Department
3Improving Access to Healthy Food: A Community Planning Tool
Then, the group should develop a process to prioritize these stated goals and agree
to address a select number.
Step 3 - Develop a planning and decision-making process. Conducting a
community food assessment should be a collaborative process involving a great deal
of group planning and decision-making. Before getting started, it is important to
develop an organizational structure and a decision-making process that the group
understands and supports.
How group members are organized and participate in the assessment should depend
on their interests, abilities and the time they have to devote to the process. Some
participants may best be suited for a broader planning or “steering” capacity ---
establishing the overall direction for the assessment, developing project policies or
goals, and identifying needed or potential project resources. Other participants may
help best as committee or task force members who can coordinate and manage day-
to-day project activities, conduct project research or bring specific questions back to
the steering committee for consideration.
Step 4 - Define the community and identify required resources. Identify
geographic (physical) boundaries for the assessment. This can be a neighborhood
or a larger area. The team should also develop a budget for the assessment process
and work to secure the necessary funding.
Step 5 – Develop the assessment and collect the information. The assessment
should identify the location and quality of the community’s existing food resources.
Determine what you want to know about the area’s food system and develop specific
questions designed to get this information. Be sure and consider all of the available
sources for finding the information (local residents, local businesses, government or
non-profit organizations, etc.). Examine the information once it is collected to see if
anything important is missing or if gaps remain. If so, you may need to develop
additional questions.
Possible Assessment Questions
• Where do residents of my neighborhood get their food? (large groceries,
corner grocery stores, schools, WIC programs, food pantries, clinics, etc.?)
• What is the quality of food available to residents?
• How does my neighborhood compare with other areas in regard to access to
nutritious food?
• What are residents’ eating habits, food purchasing habits and interest in fruits
and vegetables?
• What are the barriers to finding (or providing) healthy food choices in my
neighborhood?
Columbus Health Department
4Improving Access to Healthy Food: A Community Planning Tool
• What do residents know about preparing food in a nutritious manner?
• How much can residents learn about preparing food in a nutritious manner?
• What are the best ways to teach residents about preparing nutritious food?
• If healthy food is available in my neighborhood, why aren’t people buying it?
If healthy food is not available, why not?
• What opportunities for improvement do people see for accessing nutritious
food?
Additional Information That Might Be Useful
• Community and household demographics
• Community food assets or resources (grocery stores, food processing
facilities, community gardens, etc.)
• Community-based organizations involved in food issues
• Food and nutrition resources and services
• Information on the frequency and impact of diet-related illnesses
• Information on local policies and practices related to food issues, such as
preserving agricultural land, promoting small businesses, attracting
supermarkets, etc.
Step 6 - Present and disseminate assessment findings. Once the assessment is
complete, it is important to share the findings with the broader community. The
assessment team should identify several ways to distribute the information as
thoroughly as possible. Whether this is through community meetings, formal
presentations, leaflet drops or other methods, the goal is to inform as many residents
as possible.
The assessment results should provide valuable information about the community’s
food system and the availability of healthy food –- how much there is, what kind of
food is available, where it is located, how much it costs, if cost changes by location,
and other important information. At the same time, the assessment should also
include key information about the people who make up the community.
The results should help identify both strengths and problem areas about the
availability of nutritious food in the community. This information is important because
it provides the groundwork for the next step in the process --- selecting the best
strategies for “fixing” the problems. This next step is the development of an Action
Plan.
Columbus Health Department
5Improving Access to Healthy Food: A Community Planning Tool
Part 2. Developing an Action Plan
An Action Plan contains the specific strategies that will be used to increase
access to healthy foods, and the specific ways in which those strategies will be put
together. Specifically, the plan should include information on the following for each
strategy that is included:
• What action or change will occur?
• Who will carry out the action or change?
• When will the action or change take place?
• What resources (money, staff, etc.) are needed to carry out the action or
change?
Many promising community initiatives fail because of shortcomings in action
planning. Identifying “problems” through a community assessment is an important
step, but all of the valuable information that the assessment provides is wasted
unless a plan is developed and carried out to address the identified problems.
Work on creating an action plan should begin as the assessment process is nearing
completion. This will help ensure that none of the project’s momentum is lost as the
emphasis shifts from the assessment phase to the action phase. Once the
assessment is complete, project members then can quickly and seamlessly move
into action plan development.
How to write an Action Plan
Step 1. Determine who should be involved. As with the assessment process, it is
also important to involve the community in developing solutions. Consider
representatives from the business community, schools, youth organizations, parent
groups, media, religious organizations, social service organizations and health
organizations. Some specific community members might include:
• Influential officials affected by your initiative (e.g., city officials responsible for
enforcing regulations, approving permits, etc.);
• People who are directly involved in the problem (e.g., local high school
students and their parents who can speak personally about issues related to
food access and consumption); and
• Members of the community’s ethnic and cultural groups.
Some of the same people involved in the assessment phase will undoubtedly
continue their involvement by helping to develop the action plan. This can be
extremely helpful because their participation ensures that project knowledge,
experience and expertise are retained as the project continues.
Columbus Health Department
6Improving Access to Healthy Food: A Community Planning Tool
However, it is important to note that there can (and should) be some change in the
make-up of project participants once action planning begins. New participants help
to bring new life to a project. In addition, the skills and abilities needed to develop
action plan strategies are often different from those needed in an assessment
process. Project organizers should recognize this and recruit participants that are
interested in and best suited to developing an action plan.
Step 2. Begin organizing the action plan process. This may be done by the
same people who will actually develop the action plan strategies, or it could be done
by a smaller group of project decision-makers. As the action plan process begins,
however, there should be general agreement and understanding among all involved
regarding key components:
• The Group’s Purpose. What is the group’s purpose? What will it attempt to
do? What does the group hope that the community will look like after
completion of its work? There are numerous ways to think about increasing
neighborhood access to healthy foods. These could include developing and
promoting local policies, developing nutrition programs, establishing new
locations for offering healthy foods, etc. General agreement about why the
group has formed and what it will work toward is important.
• The Action Plan Form / Format. Deciding up-front on the form and format of
the anticipated action plan can save time later. Will it be a detailed report?
Will it be an abbreviated summary of recommendations? How will it be
organized? Who is your audience? Who should receive the action plan and
how will it be used?
Step 3. Develop action plan strategies to address desired changes. Work
should now turn to developing specific strategies to address the problems you have
found in your assessment. In doing so, participants need to differentiate between an
idea and a strategy. There may be many ideas suggested for action plan strategies.
But not every idea proves to be workable. Some ideas may seem promising, but
aren’t feasible after further consideration. Criteria should be established to determine
which ideas should be further developed into actual strategies, which strategies offer
the best chance of success and which should be included in the final completed
action plan.
Potential Criteria to Help Determine
Which Ideas Can be Developed Into Action Plan Strategies
• Number of people who will benefit • How much time will be required?
• Ease / difficulty of implementing • How certain are the results?
• How much will it cost? • Is it legal?
Figure 1 contains a worksheet that can help in considering and developing action
plan strategies.
Columbus Health Department
7Improving Access to Healthy Food: A Community Planning Tool
Improving Access to Healthy Food: A Community Planning Tool
Figure 1:
Suggested Action Plan Worksheet
For Strategy Development
Action Plan Strategy ______________________________________________ Number _______ of _______
Action Steps: By Whom? By When? Resources and Support Potential Barrier or Resistance
What needs to be Who will take By what date
Resources Resources What individuals or
done? the action? will the action
Available Needed groups might resist? How?
step be done?
Step 1:
Step 2:
Step 3:
Step 4:
Step 5:
Step 6:
(Adapted from The Community Toolbox: Action Planning Form, http://ctb.ku.edu/tools/developstrategicplan/actionplanningform.jsp)
Columbus Health Department
8Improving Access to Healthy Food: A Community Planning Tool
Part 3. Evaluation
Congratulations. At this point you have:
1. Identified the availability of healthy foods as a possible community concern.
2. Completed a community assessment to determine the extent of the problem.
3. Developed an action plan to address it.
4. Put strategies in place to increase amount and type of healthy foods in your
community.
It seems like your work is complete. However, a very important piece still remains –
evaluating the performance and outcomes of the food access strategies you have put
in place.
What is an evaluation?
An evaluation is simply a process to determine whether your food access strategy is
doing what you expect it to do. It is the collection of information that helps answer
questions on how well your strategy is working.
People often think that an evaluation is a complex process –- that it has to be done
by experts in a certain way and at a certain time. However, this is not the case. An
evaluation can be done in many ways, providing that a sufficient amount of
information can be gathered to answer your questions. An evaluation can be
relatively simple and straightforward, and can be conducted by those with no special
training or experience. Most importantly, it provides the ability to get feedback on a
strategy and make the necessary adjustments.
Evaluation methods
There are many possible ways to conduct an evaluation. Some methods may be
more useful than others. For example, some methods may produce very detailed
information, but they may be costly and take time to complete. The most appropriate
evaluation method will depend on the evaluation’s purpose and a variety of other
factors affecting an individual project. Figure 2 summarizes a number of methods
that could be used to evaluate food access strategies.
What information should be collected?
The specific evaluation questions depend on the individual strategy being evaluated
and the information needed to make decisions about its performance. Are you
interested in examining your strategy’s day-to-day operations? Do you want to
specifically address customer complaints? Do you want to know if the strategy is
meeting established goals? Do you want to know the impact that your strategy is
having on those using it? You may want to know information about a number of
these questions.
Columbus Health Department
9Improving Access to Healthy Food: A Community Planning Tool
Figure 2:
Possible Evaluation Methods
Method Overall Purpose Advantages Challenges
• Can be completed • Might not get meaningful
anonymously feedback
Questionnaires, To quickly and/or easily • Inexpensive to • Wording can bias responses
Surveys, get lots of information administer • Are impersonal
Checklists from people in a non- • Can be administered • Sampling expertise may be
threatening way to many people needed
• Can get lots of data • May not get the full story
• Many sample
questionnaires already
exist
To fully understand • Gets full range and • Can take time
Interviews one’s impressions or depth of information • Can be hard to analyze and
experiences, or learn • Can be flexible compare
more about answers to • Can be costly
questionnaires • Interviewer can bias
responses
• Gets comprehensive • Takes time
To get impression of and historical • Documents or data used
Documentation how program operates information may be incomplete
Review without interrupting the • Doesn’t interrupt • Need to be clear about
program; from program routine information needed
application review, • Information already • Data restricted to what
finances, memos, exists already exists
documentation, etc. • Few biases about
information
• Can be difficult to interpret
To gather accurate • View program observed behaviors
Observation information about how activities as they are • Can be difficult to categorize
a program actually actually occurring observations
operates, particularly • Can adapt to events • Can influence behaviors
about processes as they occur • Can be expensive
To explore a topic in • Quickly and reliably • Can be hard to analyze
Focus Groups depth through group gets common responses
discussion, e.g., about impressions • Need a good facilitator for
reactions to an • Can be an efficient safety and closure
experience or way to get range and • Difficult to schedule 6-8
suggestion, depth of information in people together
understanding common a short time
complaints, etc. • Can convey key
program information
(Adapted from Basic Guide to Program Evaluation, Overview of Methods to Collect Information. Carter
McNamara, MBA, Ph.D., http://www.managementhelp.org/eval.org/evaluatn/fnl_eval.htm#anchor1585345)
Columbus Health Department
10Improving Access to Healthy Food: A Community Planning Tool
Questions to Consider in Determining
Evaluation Information Needed
• Why is the evaluation being done? What are the specific issues the strategy
trying to address?
• What are the stated goals of the strategy being evaluated? What specific
changes are expected as the result of your strategy?
• What kind of information do you need to make decision(s)?
• How accurate will the information be for the selected evaluation method? How
accurate does it need to be for you to make necessary decisions?
• From whom should you collect information?
• Will the method selected get you all of the information you need? Do you
need to use more than one method?
• When do you need the information? Are there time constraints?
• What resources are needed to collect the information?
• Who will be reviewing the information? Who is the audience?
Figure 3 provides an example of a worksheet showing how some of this type of
information can be organized to help in evaluation efforts.
The Importance of Engaging the Community
Throughout this document, we have discussed the importance of involving the
community in the process –- using neighborhood residents to help develop both the
Community Food Assessment, and resulting Action Plan. Community assistance can
also be helpful in obtaining the information necessary to evaluate the success of
Action Plan strategies.
This community engagement helps people become involved in decisions that affect
their lives. Those people most affected need to be an integral part of the decision-
making process. This is particularly important in efforts to improve access to healthy
food at the neighborhood level.
Encouraging the community to examine the area food system will help to identify and
mobilize the kind of local human and material resources that are needed to bring
about sustainable community change. These efforts should result in programs that
are small enough to manage, yet large and durable enough to produce a significant
impact on the neighborhood food system.
Columbus Health Department
11Improving Access to Healthy Food: A Community Planning Tool
Improving Access to Healthy Food: A Community Planning Tool
Figure 3:
Suggested Evaluation Worksheet
1. Strategy Introduction of Healthier Food Items at Corner Grocery Store
What is being evaluated?
Which specific food access strategy?
5. Data Collection
2. Questions 3. Evidence 4. Time Frame Sources: Methods: Results: Results:
What do we want to How will we know it? When must data be Who will have the How will the info be Who will get How and
know? collected? information? gathered? results? when?
1. Is the grocery 1a. Number and type of 1a. Grocery manager Observation, interview
offering healthier items displayed or checklist
items? b. Product inventory b. Grocery manager Checklist
2. How much is 2a. Product inventory 2a. Grocery manager Documentation review
available? b. Delivery schedules b. Food distributor Documentation review
3. Are people 3a. Sales receipts 2a. Grocery manager Documentation review
buying these items? b. Customer b. Grocery customers Survey or interview
information
4. How often? 4a. Delivery schedules 4a. Food distributor Documentation review
b. Restocking frequency b. Grocery manager Interview
c. Customer information c. Grocery customers Survey or interview
5. Are items 5. Price comparisons with 5. Area groceries & Survey
affordable compared other groceries managers; grocery
to other locations? associations
(Adapted from University of Wisconsin Cooperative Extension, Program Development and Evaluation. http://www.uwex.edu/ces/planning/pdf/EvaluationPlanWorksheet.doc)
Columbus Health Department
12Improving Access to Healthy Food: A Community Planning Tool
Who should be involved?
Communities are made up of people with a broad range of abilities from different
backgrounds and cultures. Using a variety of people to carry out the process helps
ensure that a wide range of expertise, opinions and ideas are brought to the table.
Consider the value of inviting the following:
• Community residents are the foundational core of community action
planning. They know their neighborhood and can identify their community’s
assets, deficiencies, and needs. They provide an authentic knowledge base
of community consumption patterns and represent the community’s interests.
Residents should be involved in each step of the process to bring more
healthy foods into their neighborhood.
• Including ethnic interests will encourage a broader scope in both the
assessment and design of any resulting strategies. These interests can
provide useful information regarding cultural influences on food consumption
patterns. For example, foods that are consumed or sold in African American
communities may not be the same as foods that are popular in Hispanic
neighborhoods.
• The local health department has access to important health information and
government funding, and has experience in community-based initiatives. It
can be a resource for the community by providing nutrition information,
disease statistics, and information on various government grants. It can
advise project organizers on initiative planning, and act as a liaison between
the community and other government agencies.
• The local clergy are often well-established and well-respected community
leaders. Their perspective on the community’s assets and needs can be
helpful in designing the assessment. Because they are already in positions of
leadership, they can be helpful in leading community meetings, motivating the
community to get involved and promoting possible food access strategies.
• Civic organizations and neighborhood commissions like the YMCA, local
neighborhood associations or councils, American Red Cross, etc., may have
staff, leadership experience and funding for planning and developing an
assessment or action strategy. Since these organizations already have an
established community base, they may be able to provide the project with
volunteer assistance.
• Schools/colleges are key educators. They may provide materials, programs
or classes about healthy foods, which can help create an awareness and
market for such foods. They are familiar with food consumption patterns and
needs of the community and can help promote new gardens, markets, etc.
Columbus Health Department
13Improving Access to Healthy Food: A Community Planning Tool
• Grocery store owner(s) can provide background information about retail
prices, food availability, shelf life of food, food distribution issues, present food
consumption patterns, etc.
• Community gardeners have a strong interest in healthy food and have
experience in working with community members.
Getting People to the Table
Network. Talk with people who are known to be interested in the issue of improving
access to healthy food. Find other organizations, groups and individuals that share
some of the same concerns and get in touch with them. Form partnerships with other
groups if necessary. Go to the meetings of other groups and to places and events
where people gather. This is particularly important if involving different cultural and
ethnic groups, youth, seniors and others who may not come to you. Remember to
ask -- most community volunteers become involved because they were asked to
participate by a friend, a family member, or a neighbor.
Develop a newsletter and leaflets. Newsletters keep group members in touch and
inform the rest of the neighborhood about the project. Delivering leaflets to a wide
range of people in a neighborhood will help attract new members. Create one leaflet
that includes talking points about the issue. It can be a helpful recruitment tool.
Go door to door with information. Going door-to-door and talking with neighbors
may be a great place to begin community awareness. You can also recruit interested
neighbors to your project team.
Plan an event. Events (block parties, healthy foods festival, etc.) are planned get-
togethers that help to create relationships between community members, local and
state agencies, and private and non-profit organizations. An event focused on
access to healthy foods should include community residents, local grocers, and
interested neighborhood and community organizations and agencies.
Community residents working together provide a unique opportunity to identify and
develop new or additional neighborhood sources of healthy foods. In going through
the process, residents can develop leadership and public speaking skills, learn more
about their community, help improve the local economy, and make the community a
better place to live. Those involved in these efforts provide a role model for others in
showing how community involvement can be a positive force for change in helping
residents to live healthier and more fulfilling lives.
Columbus Health Department
14Improving Access to Healthy Food: A Community Planning Tool
EXAMPLE FOOD ACCESS STRATEGIES
Neighborhoods around the country have been involved with increasing community
access to healthy foods. Many different strategies to address the issue have been
developed. This section contains a general overview of strategies that have been
used by some communities.
In reviewing this information, remember that it is important to thoroughly analyze the
completed assessment before considering a specific action plan strategy. The
assessment results will help determine whether a strategy from this section may be
useful.
For example, if an assessment shows there are no gardens in the area, but a number
of people who enjoy gardening, you may want to consider creating a community
garden. If people love their corner grocery but want healthy food added to the
inventory, then working with the corner grocery is one strategy that should be
considered.
Based on its assessment, a community may have to develop and implement more
than one action strategy. If so, prioritize and begin with the strategy that’s the best
choice for your community.
Increasing neighborhood access to healthier food may be hard work, but it can be
very satisfying. It can bring the neighborhood together in a way that will make the
necessary work worthwhile.
Columbus Health Department
15Improving Access to Healthy Food: A Community Planning Tool
Strategy 1:
Working With Corner Grocery Stores
Being able to find healthy food in smaller neighborhood stores is often a problem.
Small corner grocery stores often do not have a wide selection of food choices and
their prices are sometimes higher than those in a supermarket. However, a
supermarket may be located many miles away, and available transportation to the
supermarket may be expensive or non-existent.
Existing groceries are an obvious starting point improving availability of healthy
foods. Money is not needed to start a new grocery -- rent, insurance, utilities, etc. are
already covered. What is needed are ways to help existing grocery owners; they
need to know that customers want healthier food choices and that offering them can
be profitable.
This strategy of working with corner groceries
may work best when:
• You have corner stores whose owner/operator you know and
can talk with about the issue of wanting to see healthy food
added to their inventory.
• You have an experienced store owner/operator, with thorough
business knowledge and a commitment to the neighborhood.
• You can give information to the owner/operator that shows the
neighborhood supports this idea and wants to help.
• You can offer expertise of someone in the industry who can
provide technical assistance and training for the storeowner,
operator or employees regarding what they will need to change
to add healthy food to their inventory.
• You can help the storeowner find space for the additions you
want to add to the market.
• You can help the store owner/operator familiarize existing
customers with the new additions to the inventory. For
example, this can be done by providing food samples or
cooking demonstrations.
•
• You can help the store owner/operator find financial assistance
for any changes the grocery needs to make.
Columbus Health Department
16Improving Access to Healthy Food: A Community Planning Tool
Strategy 2:
Working with Existing Supermarkets
Establishing a relationship with existing supermarkets to increase access to healthy
foods can be easier than bringing in new supermarkets. Nationwide, supermarkets
have added new offerings, often as the result of consumers voicing their desire to
purchase these products.
If an assessment shows there are existing area supermarkets, but that they are not
offering affordable healthy food, working with them is a good option. Access to
transportation also should be considered. If transportation to existing supermarkets
is available or can be arranged, then working with these facilities may be a viable
strategy.
These efforts can begin with a meeting between local residents and supermarket
officials to discuss the community’s needs and what the supermarket can offer in
response to these needs. For example, in some communities the supermarket may
be carrying healthy foods, but the community lacks accessible transportation. In
other communities, the supermarket may not be carrying locally grown produce and
market officials need to be made aware of a demand for such a product.
This strategy of working with existing supermarkets
may work best when:
• You have an existing supermarket that is easily accessible to a
large segment of the community via a variety of transportation
methods.
• You have a strong, experienced store owner/operator, with a
thorough knowledge of the business and a commitment to the
neighborhood.
• You can give information to the owner/operator that shows the
neighborhood supports this idea and would purchase foods
from his or her facility.
Columbus Health Department
17Improving Access to Healthy Food: A Community Planning Tool
Strategy 3:
Bringing New Supermarkets to a Neighborhood
Establishing a new supermarket may not be the answer for every community.
However, if a community decides the best option is to establish a new supermarket, a
task force should be created. The task force should examine all aspects of
establishing a potential facility, including determining a possible location, and
managing the community interests involved with research, funding, site selection,
market development, etc. Consequently, the task force should be comprised of
experts from the public, private and civic sectors, as well as community residents.
This strategy of establishing a new neighborhood supermarket
may work best when:
• You can bring together a task force of interested community
residents to explore establishing a supermarket in their
neighborhood.
• You can collect or produce data to educate business,
governmental, civic and private agencies about the assets and
needs of the community, including health-related concerns,
cultural demographics and economic indicators.
• You can identify areas for supermarket development and
promote them to real estate developers and the supermarket
industry.
• You can identify public/private partnerships to explore sharing
of investment, risk, responsibility and reward related to
establishing a new supermarket.
• You can identify community development funding grants or
donations available from federal, state, city, private or non-profit
organizations.
Columbus Health Department
18Improving Access to Healthy Food: A Community Planning Tool
Strategy 4:
Starting a Food Cooperative
A food cooperative may be an ideal resource for a neighborhood working to increase
access to healthy foods. A “Co-op” encourages employee and community member
participation in most of the important decision-making processes. A food cooperative
can engage the community on many levels — from facility ownership, to
management decisions, to simply creating job opportunities — and it keeps
resources in the community. The co-op’s emphasis on community control and
accountability creates a win-win situation for both community residents and outside
interests.
Cooperatives are generally organized in four ways:
1) Worker-owned: Businesses owned and operated by employees
2) Producer-owned: Organized by small businesses, producers and farmers to
provide goods and / or services
3) Consumer-owned: Owned by the members, employees and businesses that
have invested in the cooperative
4) Purchasing / shared services cooperatives: Offer a variety of products and
services -- from food to hardware -- and can be structured in any of the ways
described in 1, 2 or 3.
This strategy of starting a food co-op may work best when:
• You can identify a committed core group of people – at least
five – who are interested in starting a co-op.
• The co-op can be centrally located in a safe and convenient
location.
• The co-op location can be leased, which is generally more
affordable and allows the community to be flexible when
adjusting to ever-changing real estate costs.
• Community members can work with the co-op manager(s) to
help in ordering healthy foods that the community will buy.
(Keep in mind varying cultural preferences for different types of
foods.)
• Continued neighborhood promotion of the co-op is possible,
through announcements in church, social gatherings, school
meetings, local papers, etc.
Columbus Health Department
19Improving Access to Healthy Food: A Community Planning Tool
Strategy 5:
Creating a Buying Club
If organizing a food cooperative is too labor / time intensive or too expensive, a
“buying club” is another way to bring healthy foods into a community. The main idea
of a buying club is for people to save money by buying food at wholesale and bulk
prices rather than at retail prices. This can be done if enough people get together so
that the food can be purchased in a higher volume.
This strategy of creating a buying club may work best when:
• You can identify seven or more families who will commit to
sharing the work, including placing orders with food distributors,
collecting money from buying club members, unloading delivery
trucks when they arrive at the drop-off site, dividing the
individual orders, notifying purchasers that their orders have
arrived, and/or delivering individual orders.
• You can identify and locate local food distributors who can
supply the buying club. (Research local distributors at
www.coopdirectory.org/distributor.html)
Strategy 6:
Food Kiosks
Food kiosks are another way for communities to access healthy foods. During the
growing season, people may see food kiosks in parking lots, by the roadside or other
public places selling seasonal foods. These kiosks are typically small structures with
one or more open sides used to sell goods like fresh sweet corn, eggs, tomatoes and
apples. Food kiosks are often a way for a local farmer or market gardener to
supplement his or her income and provide an easy way to help neighborhoods to
improve access to fresh, local foods.
This strategy of creating a food kiosk may work best when:
• The community has local gardeners and farmers that can
supply the kiosk. Local farmers and gardeners may be found
through local and statewide farm and gardening organizations,
through the state’s Department of Agriculture and on national
web-sites like www.foodroots.org and www.localharvest.org.
Columbus Health Department
20Improving Access to Healthy Food: A Community Planning Tool
• Other food distributors (i.e., food bank or private grocery) can
be located to stock and operate a community kiosk. Local food
distributors may be in the phone book, or found on-line at
websites like www.coopdirectory.org/distributor.htm.
• A centrally located site can be found that offers convenient
parking, access to pedestrian traffic and access to a bus line.
• Local municipal regulations permit the establishment of a kiosk
structure.
• Continued promotion of a kiosk is possible through the
distribution of neighborhood flyers and posters, door-to-door
canvassing, and ads in local newspapers or radio.
Strategy 7:
Farmers’ Markets
At farmers’ markets, growers sell basic produce like apples, tomatoes, collard
greens, spinach, onions and potatoes. These markets can be an important way to
revitalize business areas, support the local economy and create a sense of
community.
Farmers’ markets are a place where neighbors can chat with their friends and
neighbors. They can buy healthy food, get to know the person who grew their food,
educate their children about where food is grown -- and in an ethnically diverse
market, learn about other cultures. A farmers’ market is a colorful addition to
neighborhoods that need some stimulation to help boost the local economy. In
neighborhoods where there is little or no access to fresh, healthy food, a farmers’
market may be a necessity.
Farmers’ markets in low-income areas have special challenges. Urban market
gardeners and small farmers cannot compete with supermarket prices. At the same
time, area residents may not have the disposable income to pay higher prices for
market produce. To help with this problem, some programs have been established to
support small growers.
One such program is the federal Farmers' Market Nutrition Program (FMNP), which
provides $20 per year in coupons for free produce to low-income seniors, pregnant
women or women with young children. This modest funding can provide significant
benefits to low-income consumers and family farmers and is helpful in making it
possible for Farmers’ Markets to be located in low-income neighborhoods.
Columbus Health Department
21Improving Access to Healthy Food: A Community Planning Tool
In order to successfully establish a neighborhood farmers’ market, it may be
important to work with non-profit groups, churches, and local, state, and federal
agencies. These organizations may have access to funding, or may be able to help
with nutrition education efforts. These efforts can play a key role in encouraging
people to support farmers’ markets.
This strategy of establishing a Farmers’ Market
may work best when:
• You can identify a group interested in establishing the market.
This group should form a planning committee to consider all
aspects of market planning and establishment, including
property rental or leasing, market stand style and layout, dates
and hours of operation, etc.
• You can locate potential farms or vendors to supply the market.
• You can identify the applicable local laws, regulations and
procedures that must be followed in order to establish a
farmers' market.
• Sources of any required start-up funding can be identified.
Strategy 8:
Community Gardens
Community gardens are pieces of land where residents of a neighborhood grow food,
flowers, herbs, etc., for their personal use, for selling at Farmers’ Markets or for
donating to food pantries. Community gardens promote healthy communities and
can provide access to affordable healthy food for low-income residents. Community
gardens strengthen community bonds and create recreational and therapeutic
opportunities for those gardening. They can also promote environmental awareness
and provide opportunities for nutritional education.
This strategy of establishing a community garden
may work best when:
• Two to four who are interested in starting a community garden
are available and others will agree to join as needed.
Columbus Health Department
22Improving Access to Healthy Food: A Community Planning Tool
• You can identify a garden coordinator who has gardening
knowledge and is able to inspire and lead others.
• You can locate a suitable garden site. The site requires access
to water, direct sun for 4-6 hours a day, should be free of trash
and litter, and close to potential gardeners.
• The garden site is available for use through purchase or
multiple-year lease.
• Get permission to use the site, preferably for at least ten years
or buy the site, if possible.
• You can identify the applicable local laws, regulations and
procedures that must be followed in order to establish a
community garden.
• The garden site can be reasonably well protected against crop
loss by animals or potential vandalism.
Some Procedural Notes on Establishing
Food Kiosks, Farmers’ Markets and Community Gardens
Food access strategies that require a physical location – food kiosks, farmers’
markets and community gardens – may require organizers to work through a number
of regulatory issues before they can be successfully established. These regulatory
issues generally involve two factors: 1) the specific items that the facility will offer,
and 2) the facility’s physical structure and desired location.
1. Items Offered
In Ohio, food licensing and facility inspection requirements may apply in establishing
some food access strategies. Generally, these requirements depend on the specific
items produced or available for sale.
• Fresh fruits and vegetables and unprocessed foods can be sold without a
required inspection or license. Although food safety laws do not require
inspections as a protection against illness, health officials caution that
customers should always wash these foods thoroughly to ensure that any
contaminants on the food’s skin, rinds, and outer covering be removed.
Columbus Health Department
23Improving Access to Healthy Food: A Community Planning Tool
• “Cottage Industry” foods (baked goods; canned jams, jellies, honey, etc.)
are regulated by the U.S. Department of Agriculture (USDA), primarily as a
protection against disease from improper processing (i.e., botulism). These
foods must be produced at a registered location to be legally sold to the
public.
• Local health departments serve as the local arm of the USDA and are
responsible for the inspection and licensing of retail food establishments and
food sales. More specifically, facilities selling any “processed” foods
(involving slicing, dicing, liquefying, pureeing, cooked) are subject to plan
review, inspection and licensing by local health departments. The primary
concern here is the possible bacterial contamination of foods and resulting
illness from issues of improper utensil use and temperature control.
2. Physical Structure and Location
In Columbus, the procedures for establishing any new site for offering healthy foods –
whether a kiosk, farmers’ market or community garden – depend on whether the
location is on private property or public right-of way. Different city agencies have
regulatory responsibility depending on a property’s location.
On Private Property: The Columbus Building Services Division (BSD) of the
Department of Development administers the zoning and building codes that regulate
land use construction to help ensure the health, safety and welfare of its residents,
while protecting the rights and privileges of property owners. The division reviews
building plans, licenses contractors, coordinates re-zonings and variances, conducts
inspections and issues building permits.
Many factors must be considered before any potential food access strategies can be
established. Community organizers must be careful to work through all of these
factors with appropriate city regulatory agencies to ensure that the anticipated land
use is both appropriate and legal. Though there may be a variety of land use issues
to consider, BSD officials say they can generally be placed into two categories:
How is the property currently zoned?
The city’s zoning code includes more than 35 different zoning districts, most of which
fall into residential, commercial, and manufacturing classifications. The zoning
district determines the permitted land use and establishes standards for developing
the property (i.e., setbacks, parking requirements, etc.).
While food kiosks, farmers’ markets and community gardens are permitted in most
commercial zoning districts, there may be specific use restrictions and development
standards that could prohibit these uses in some instances. Community organizers
should carefully consider all the elements of any proposed food access strategy and
prepare a thorough description for review by zoning staff.
Columbus Health Department
24Improving Access to Healthy Food: A Community Planning Tool
Some of the many factors that need to be considered by zoning officials include:
• How you wish to use the property
• Hours of operation
• Anticipated sales
• Site configuration
• Required parking
• Lighting
• Screening
• Storage requirements
• Display areas
A request for property re-zoning or a variance to accommodate a proposed use may
be required. If so, BSD officials would require a site plan to scale, showing the
property’s configuration and proximity to streets and alleys, the location of any
existing and proposed buildings or parking areas, and other details.
What specifically will be placed on the property?
Any buildings, fences and paved areas may require permits. Building and zoning
codes regulate the construction and placement of various structures. The permit
process ensures that structural, electrical, grading, drainage, and construction
methods are in compliance with applicable codes. Information regarding the
permitting and zoning processes, as well as on-line forms and contact information, is
available on the Columbus city website: www.columbusonestopshop.com.
On City Right-of-Way: The Columbus Department of Transportation maintains city
streets, highways, alleys and bridges, and regulates the use of city “rights-of-way.”
City rights-of-way typically extend beyond the limits of roadway pavement to include
sidewalks, ditches, utility strips, etc.
Transportation officials report there are various permits and permit-like processes
that may be required, depending on what food access strategy may be desired,
where it may be established, and for how long. These are handled by the Right-of-
Way Services unit, which reviews individual applications. Officials say that permits
are generally granted if the proposed use will not interfere with the health, safety or
general welfare of the public.
However, because there are many factors to consider, Transportation Division
officials strongly advise anyone wishing to utilize any portion of the public-right-of way
to contact the office well in advance of the proposed implementation date. Once
contacted, Transportation Division officials will walk residents through the process.
Those with questions on use of city rights-of-way can call the Transportation
Division’s Permit Section at 645-7497, or E-mail the Division at:
streetsofcolumbus@columbus.gov.
Columbus Health Department
25Improving Access to Healthy Food: A Community Planning Tool
Strategy 9:
Transportation
Many people have difficulty accessing fresh, healthy foods because of transportation
limitations. Lower than average vehicle ownership, transportation policies that favor
automobile use and the trend for supermarkets to be located in middle/upper income
communities can all create significant hurdles toward providing equal access to
healthy foods. According to “Transportation and Food: The Importance of Access” by
the Center for Food and Justice:
• There are typically 3 times as many supermarkets per capita in upper and
middle-income neighborhoods than in low-income neighborhoods;
• There are fewer full service food markets per capita in neighborhoods with
predominately low income, minority, or immigrant residents; and
• Low-income households are 6 to 7 times more likely than other U.S.
households to not have a car.
Since “chain” supermarkets and farmers’ markets are scarce in some communities, it
can be difficult for residents to travel to locations where they can buy healthy foods
like fruits and vegetables.
Overcoming community transportation barriers can be very difficult. Transportation
issues can require the involvement of local and state government agencies and
officials, as well as private businesses. Problems can range from lack of
transportation access (no sidewalks, bike lanes, and bus lines, etc.) to an economic
issue of transportation affordability. Solutions to these problems can take years to
identify and to address successfully.
However, those wishing to consider this issue can explore some relatively simple
solutions. They include:
• Working with store or market owners to establish shuttle service for potential
customers.
• Promoting new bus routes with city or regional transportation officials.
• Providing reduced or subsidized travel vouchers for participating cab or bus
services.
• Establishing a bike-sharing program in the community. These cooperative,
free-bike programs have been established in many U.S. and European cities.
Though the programs vary, all generally provide free bicycles at various
community locations, which can be used temporarily by residents for little or
no cost. The bikes are specially designed and marked. When finished,
residents return the bicycles to selected community locations.
Columbus Health Department
26You can also read